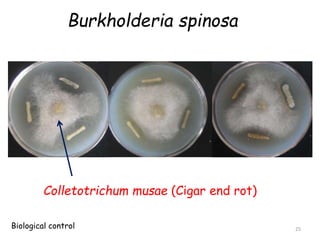
Burkholderia spinosa
Colletotrichum musae (Cigar end rot)
25
Biological control
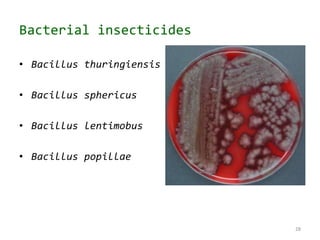
Bacterial insecticides
• Bacillus thuringiensis
• Bacillus sphericus
• Bacillus lentimobus
• Bacillus popillae
28

This document discusses bacteria, including their classification, structure, and industrial importance. It classifies bacteria according to their shape, arrangement, gram staining, habitat, metabolism, oxygen requirements, and whether they are beneficial or harmful. It then discusses the industrial applications of bacteria, including nitrogen fixation, bioremediation, biological control, plant growth promotion, and uses in dairy, biotechnology, antibiotic production, fermentation, and more. Many examples of specific bacteria used industrially are also provided.